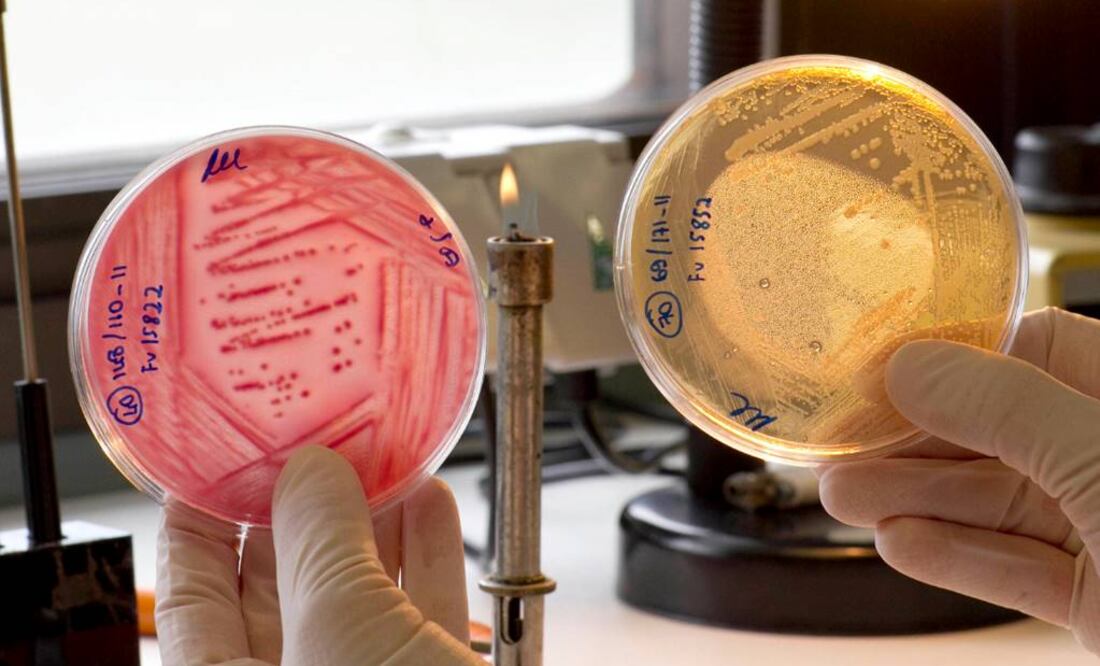
Utiliza una proteína para sujetarse a la superficie del tracto urinario. Foto: Archivo

Más Información

Congresistas demócratas de EU rechazan amenazas de Trump sobre intervención militar en México; envían carta a Marco Rubio

Tren Interoceánico: Sobreviviente relata caos, heridos y dos horas de espera tras descarrilamiento; fue una experiencia “siniestra y dolorosa”

SIP pide a México "romper el ciclo de impunidad" tras nuevo asesinato de periodista; caso Carlos Castro evidencia vulnerabilidad del gremio
La bacteria intestinal E.coli puede viajar a través de la uretra hasta la vejiga y causar "dolorosas infecciones" urinarias, según describe un trabajo de la Universidad de Basilea (Suiza), publicado este lunes en la revista Nature Communications.
Timm Maier, Beat Ernst y su grupo detallan cómo la bacteria utiliza una proteína para sujetarse a la superficie del tracto urinario por medio de una "sofisticada técnica", lo que dificulta su expulsión del organismo, señala un comunicado de la universidad suiza.
"Muchas mujeres han experimentado cuán dolorosa puede ser una infección de vejiga. La quemazón durante la micción y una necesidad constante de orinar son sus síntomas típicos. La principal causa de las infecciones recurrentes del tracto urinario es una bacteria que se halla en la flora intestinal, la Escherichia coli", sostiene la nota.
El equipo de Basilea, que ha contado con la colaboración de la Escuela Politécnica de Zúrich, ha observado que la bacteria se ayuda de la proteína FimH para llegar hasta la uretra y evitar ser expulsada.
El patógeno cuenta con largos apéndices, similares a cabellos, que se convierten en "pequeños garfios" cuando esa proteína está unida a sus extremos.
De ese modo, logra adherirse a la superficie celular del tracto urinario, de donde resulta difícil expulsarla.
"Gracias a la combinación de diversos métodos biofísicos y bioquímicos, hemos sido capaces de elucidar el comportamiento de enlace con la proteína FimH con mayor detalle que nunca hasta ahora", afirma Rudolf Glockshuber, de la Escuela Politécnica de Zúrich.
Los investigadores subrayan que las infecciones del tracto urinario son el segundo motivo más común para recetar antibióticos, por lo que resulta útil estudiar alternativas terapéuticas en vistas a evitar un aumento de las resistencias a esos medicamentos.
kal
Noticias según tus intereses
[Publicidad]
[Publicidad]